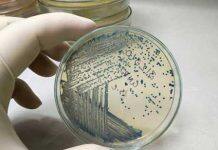
Revealing what makes bacteria life-threatening

University of Queensland renews VC’s contract
The University of Queensland Senate has extended the tenure of Vice-Chancellor Professor Deborah Terry AC, renewing her contract for five years, until February 2029.
Monash academic honoured with top national teaching award
A Monash academic has been presented the prestigious 2023 Australian University Teacher of the Year award for her outstanding contributions to teaching excellence.
Upcycling fish scales for water pollution control and encryption
Fish is commonly consumed but many may not be aware that the food and aquaculture sectors generate a huge amount of fish scale waste from processes such as preparation, canning, filleting, salting and smoking.
Laser light puts health diagnoses a breath away
Researchers at the University of Adelaide have brought medical diagnoses via breath analysis a step closer with proof-of-concept testing of the technology.
NUS Law students win regional championship of international environmental law moot
A team of NUS Law undergraduates comprising Li Minghan, Han Ying Jie and Kelly Cheung beat 25 other teams to emerge as champions in the Southeast Asian regional rounds of the...
Unravelling the genetic and environmental influences on trust
Trust, a cornerstone of human interaction, has a significant genetic component, according to new research.
Revealing what makes bacteria life-threatening
Queensland researchers have discovered that a mutation allows some E. coli bacteria to cause severe disease in people while other bacteria are harmless, a finding that could help to combat antibiotic resistance.
From mountain views to village visits: Exploring the many facets of Yunnan’s healthcare
Traversing a towering mountain in China’s southwestern Yunnan province, witnessing the spirit of collaboration behind its local healthcare services and exploring the intricacies of Traditional Chinese Medicine (TCM)...
This is how to increase EV uptake in developing nations
There’s a huge untapped market for electric vehicles in developing nations.
Former Dutch minister and renowned gastroenterologist joins NTU as Vice President of Research
NTU Singapore appointed Professor Ernst Kuipers, a renowned gastroenterologist, healthcare executive, and former Minister of Health, Welfare and Sport for The Netherlands, as NTU’s new Vice President (Research).